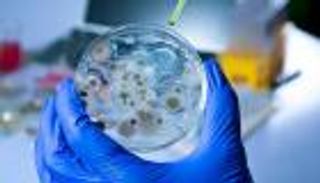
تغير المناخ يُفقد البشر أهم سلاح في مواجهة الفطريات (خاص)

تمويل الـ35 تريليون دولار.. العالم في "مهمة استثنائية" لإنقاذ المناخ

حذرت الوكالة الدولية للطاقة المتجددة من أن العالم الآن خارج المسار الصحيح لتحقيق أهدافه المناخية ومنع أسوأ كارثة. .
في تقرير سابق لها، حذرت الوكالة الدولية للطاقة المتجددة من أن العالم الآن خارج المسار الصحيح لتحقيق أهدافه المناخية ومنع أسوأ تأثير لحالة الطوارئ المناخية.
وقالت الوكالة الدولية للطاقة المتجددة فى تقريرها الذي نشرته فى مارس/أذار الماضي إنه يجب القيام بعمل كبير لإعادة توجيه المسار الحالي وذلك لن يتطلب فقط سياسات مناخية أكثر طموحًا من الدول في جميع أنحاء العالم، بل ستكون هناك حاجة إلى زيادة كبيرة في الاستثمار وزيادة الدعم العالمي للتحول الأخضر في الدول النامية والفقيرة.
وكشف التقرير أنه ستكون هناك حاجة إلى تمويل إضافي بقيمة 35 تريليون دولار في التقنيات الانتقالية بحلول نهاية العقد لخفض الاحتباس الحراري إلى 1.5 درجة مئوية طبقا لأهداف اتفاقية باريس.
وأقرت المنظمة بالتقدم المحرز في السنوات الأخيرة خاصة في قطاع الطاقة حيث تمثل الطاقة المتجددة الآن 40٪ من الطاقة على مستوى العالم. ومع ذلك تعد معدلات الطاقة الخضراء أقل بكثير من الكمية المطلوبة للالتزام بحد 1.5 درجة مئوية.
ولتحقيق الأهداف المطلوبة للحد من تغير المناخ ، يجب زيادة مستويات الطاقة المتجددة من حوالي 3 آلاف جيجاوات اليوم إلى أكثر من 10 آلاف جيجاوات بحلول عام 2030. وقد تركز معظم التقدم حتى الآن في عدد قليل من المناطق. وتمثل الصين والاتحاد الأوروبي والولايات المتحدة ثلثي إجمالي انتاج الطاقة الخضراء الجديدة في عام 2022 بينما يتخلف العديد من الاقتصادات النامية عن الركب، ولا يزال الكثيرون يعتمدون على الوقود الأحفوري كمصدر رئيسي للطاقة.
وعلى الرغم من الوعود الكبيرة من الاقتصادات المتقدمة في العالم لدعم تطوير الطاقة الخضراء في الدول ذات الدخل المنخفض عقب قمم المناخ ومؤتمرات الأطراف إلا أن هناك القليل من الاستثمار.
الوقود الأحفوري
ويشعر الخبراء بالقلق من أنه لا يزال يتم ضخ الكثير من الأموال في مشاريع الوقود الأحفوري ، والأسوأ من ذلك، أن توافر الوقود الأحفوري بفضل التقنيات الجديدة في الاستخراج يمكن أن يؤدي إلى استمرار الاعتماد على النفط والغاز والفحم ويقلل من استثمار الشركات في مشاريع الطاقة المتجددة.
وقال تقرير لموقع أويل برايس أنه ربما لا يظهر ذلك بوضوح في قطاع الغاز الطبيعي ، الذي شهد انتعاشًا في العام الماضي لأن الابتعاد عن الغاز الروسي سلط الضوء على اعتماد أوروبا على الطاقة الروسية، وسرعان ما بحثت الولايات المتحدة وأوروبا في مكان آخر عن إمدادات الغاز ووضعت خططًا لبنية تحتية جديدة للغاز الطبيعي المسال لضمان أمن الطاقة لكن يعتقد الكثيرون أن هذه الخطوة تعكس اعتمادًا مفرطًا على الغاز بدلاً من البدائل المتجددة.
وجاء تقرير الوكالة بعد وقت قصير من نشر تقرير الأمم المتحدة والذي حث الحكومات على العمل بشكل أكثر واقعية بشأن تغير المناخ.
واقترحت الهيئة الحكومية الدولية المعنية بتغير المناخ التابعة للأمم المتحدة أن الاجراءات الحالية لا تكفي لمنع حدوث أزمة مناخية حادة ، خاصة إذا استمرت الدول في إطلاق كميات هائلة من غازات الاحتباس الحراري.
وأوضح أنطونيو جوتيريش، السكرتير العام للأمم المتحدة، أن "القنبلة المناخية الموقوتة تدق وأن تقرير الهيئة الحكومية الدولية المعنية بتغير المناخ هو دليل إرشادي لنزع فتيل القنبلة المناخية الموقوتة وإنه دليل بقاء للبشرية.
وبعد التقرير، كشف الاتحاد الأوروبي عن خطط لتكثيف أهداف الطاقة المتجددة لعام 2030 وهذه الخطوة ليست فقط استجابة للحاجة إلى منع حدوث حالة مناخية مدمرة ولكن أيضًا لضمان أمن الطاقة في المنطقة على المدى المتوسط من خلال تقليل اعتمادها على الطاقة الروسية.
وتوصل المجلس والبرلمان الأوروبيين إلى اتفاق مؤقت لتوفير 42.5٪ من طاقة الاتحاد الأوروبي من مصادر متجددة بحلول عام 2030. وهذا يحل محل هدف 2018 بحصة 32٪ والاقتراح لا يزال ينتظر الموافقة من الدول الأعضاء.
ولتحقيق الحياد الكربوني بحلول عام 2050، يهدف الاتحاد الأوروبي إلى خفض صافي انبعاثات غازات الاحتباس الحراري بنسبة 55٪ على الأقل بحلول نهاية العقد. ومع ذلك ، فقد أظهر الانقطاع المفاجئ لإمدادات الغاز في المنطقة ، في أعقاب حرب أوكرانيا والعقوبات اللاحقة على الطاقة الروسية، الحاجة إلى تسريع استثمارات الطاقة المتجددة.
وأظهرت التقارير الأخيرة حول التقدم المحرز في التحول الأخضر وتأثيره على تغير المناخ أنه لا يتم عمل ما يكفي في جميع أنحاء العالم لتجنب أزمة المناخ في حين أن العديد من الدول قد حددت أهدافًا لإزالة الكربون والطاقة المتجددة إلا أن العديد منها لا يتصرف بالسرعة الكافية لتحقيق هذه الأهداف ، والعديد من الدول النامية لا تملك الموارد اللازمة لمتابعة التحول الأخضر.
وفي حين أن الأهداف الأكثر طموحًا من الاتحاد الأوروبي هي خطوة في الاتجاه الصحيح ، إلا أن هناك حاجة إلى سياسات مناخية أقوى وتمويل أكثر أهمية على المستوى العالمي لضمان تحقيق أهداف المناخ وتجنب حدوث أزمة.